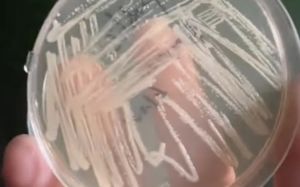

-
조수원기자2025.11.15 22:38:36
-
전병훈기자2025.11.15 22:27:47
-
안경남기자2025.11.15 21:42:25
-
이창환기자2025.11.15 22:24:11
-
류난영기자2025.11.15 18:31:02
-
이종희기자2025.11.15 19:57:53
-
김지훈기자2025.11.15 22:27:47
-
김건민 인턴기자2025.11.15 21:42:25
-
권성근기자2025.11.15 22:24:26
-
손정빈기자2025.11.15 16:26:41
-
권성근기자2025.11.15 20:38:33
-
나나 집에 강도 들어…"모친 심각한 부상, 나나도 다쳐"
이재훈기자2025.11.15 15:29:03
-
윤서진 인턴기자2025.11.15 21:42:25
-
안호균기자2025.11.15 20:00:20
-
이정필기자2025.11.15 20:38:33
-
윤서진 인턴기자2025.11.15 20:00:28
-
울산 붕괴사고 마지막 희생자 빈소…유족은 말없이 고개 숙였다
구미현기자2025.11.15 19:59:49
-
이주영기자2025.11.15 20:44:51
-
송혜리기자2025.11.15 16:26:41
-
권혁진기자2025.11.15 20:00:28
-
신항섭기자2025.11.15 21:36:50
-
여동준기자2025.11.15 21:36:45